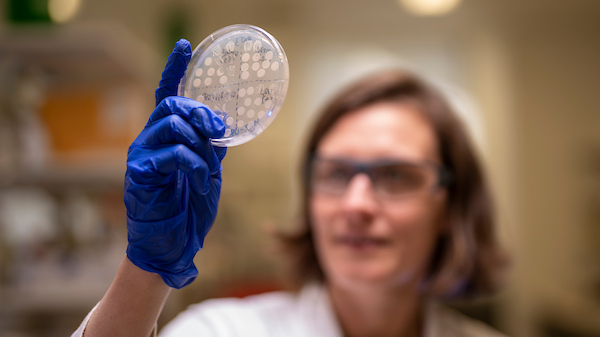

Australian National University
about
Trusted intellectual powerhouse of research and education
The Australian National University’s (ANU) mission is to provide world-class research and education for Australia and our region, and to hold and shape conversations that prepare us for a better future.
ANU is unlike any other university in Australia as it was founded through federal legislation in the aftermath of World War II. Located in the nation’s capital city, the University’s founding mission in 1946 was to be a national resource – a trusted intellectual powerhouse of research and education that would advance Australia’s capability and position on a global scale.
That vision – to support the development of national unity and identity, improve our understanding of Australia and our neighbours, and provide the nation with world-class research and education – has been the University’s mission ever since.
ANU works with government, the private sector and other research institutes to explore, investigate and develop ideas and solutions to major issues facing Australian society and the world.
The academic staff are global leaders in their fields, whether it be in the sciences, business and economics, public policy or the arts.
expertise
Multidisciplinary expertise
ANU brings a unique combination of scientific, technical, social and cultural expertise to the Rio Tinto Centre for Future Materials. As Australia’s first and only national university, ANU has a long-standing commitment to research that advances both innovation and societal good making it ideally placed to contribute to the Centre’s mission of transforming materials science for a decarbonised future.
Science and technology for materials transformation
ANU researchers are internationally recognised in areas critical to the development and deployment of next-generation materials, including:
- High-resolution materials characterisation – World-leading capabilities in CT imaging, AI-driven analysis, and digital materials platforms for understanding structure-property relationships at unprecedented resolution.
- Advanced materials for sustainable processing – Research into mineral transformation, clean metallurgical processes, and materials for low-emissions manufacturing.
- Biological Sciences for sustainable extraction and remediation – Harnessing the power of plants and microbes to develop environmentally friendly methods for extracting and recycling critical minerals and rare earth elements. This includes studying natural mechanisms of resource uptake and separation to inspire scalable, low-impact technologies for resource recovery and site remediation.
- AI and data science for materials innovation – Pioneering use of machine learning and digital twins to accelerate materials discovery, improve ore traceability, and optimise performance across complex value chains.
- Energy systems and storage – Research across battery chemistry, solar materials, hydrogen systems, and lifecycle design for future energy networks.
Cultural, societal and First Nations leadership
What sets ANU apart is its integrated expertise in the social and cultural dimensions of technology. Our scholars work across disciplines to ensure that new materials and technologies are adopted in ways that are ethical, inclusive, and locally meaningful. This includes:
- Social science and policy expertise – Insight into the societal impacts of material transitions, community engagement models, and regulatory innovation.
- First Nations knowledge systems – ANU is home to many of Australia’s leading Indigenous researchers and brings the Centre its deepest engagement with First Nations perspectives. We work with Country, not just on it—ensuring that new material futures are built with Indigenous voices, values and land custodianship at their core.
Training future leaders
ANU invests deeply in people. Through interdisciplinary PhD programs, Indigenous research fellowships, and student-led innovation platforms, we train the next generation of scientists, engineers and thought leaders to operate at the nexus of technology, society and sustainability.
Shaping the future together
As the Australian partner in the Centre, ANU plays a pivotal role in connecting local and global perspectives. Our contributions span lab to landscape – from atomic-scale imaging of ores to co-design of new circular supply chains and partnerships with Indigenous communities. This integrative strength is essential to delivering the Centre’s vision of materials innovation that is not only technically excellent, but also socially just and future ready.
quote
“Impact is when we catalyse a community around new research — when it becomes a sustainable product or service that changes society and helps meet climate and energy goals.”
Dr Victor Pantano
Chief Executive Officer of the Digital Health Cooperative Research Centre
Australian National University
discover

Prof Sujatha Raman
Professor and UNESCO Chair-holder in Science Communication for the Public Good

Prof Tim Senden
Pro Vice-Chancellor (Research Infrastructure and Entities)

Dr Victor Pantano
Director, ANU–Rio Tinto Research Partnership
Discover more

Research
Pioneering new frontiers in materials research – rethinking how we discover, extract, use and restore resources through radical science, bold ideas and deep collaboration.

Our Team
Meet world-class experts reimagining materials – from governance to social science and technical innovation – across six global partners.

Our Partners
Founded by six global partners, our Centre unites scientific excellence with industry insight – led by Rio Tinto and Imperial College London and spans four continents.
Sign up
to our newsletter
Stay informed with the latest research breakthroughs, expert insights and updates from the Rio Tinto Centre for Future Materials. Sign up to our newsletter to connect with a global community driving innovation in sustainable materials and the energy transition.